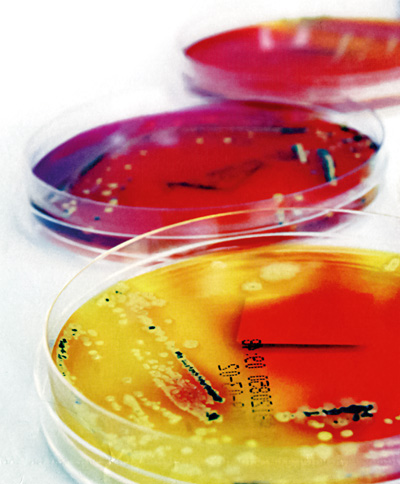
973npa_01.jpg

14 przedsiębiorstw pod kierunkiem Instytutu Tworzyw Sztucznych w Lüdenscheid przeprowadziło badania nad powłokami o właściwościach antybakteryjnych
Badania nad nowymi powłokami o właściwościach bakteriobójczych to cel zrzeszenia przedsiębiorstw powołanego przez Instytut Tworzyw Sztucznych z Lüdenscheid. Już pierwszy projekt w tym zakresie spotkał się z bardzo pozytywnym odzewem wśród zainteresowanych firm. Najnowsza edycja ma za zadanie pogłębić dotychczasowe badania.
Już pierwszy projekt badawczy pod nazwą „Powłoki antybakteryjne” spotkał się z dużym zainteresowaniem przedsiębiorstw: w okresie wrzesień 2008 r. – październik 2010 r. w programie wzięło udział 14 firm, które pod kierunkiem Instytutu Tworzyw Sztucznych w Lüdenscheid prowadziły badania polegające na analizie i ocenie 20 dostępnych na rynku chemicznych substancji antybakteryjnych pod kątem ich przydatności do zastosowania w przemyśle.
Źródło: iStockphoto.com/Linde Stewart
W lutym 2011 r. projekt wszedł w drugi etap, w którym zgodnie z wcześniej wypracowanymi metodami, przebadane zostaną kolejne substancje, przy czym przedmiotem zainteresowania będzie również kwestia żywotności powłok i kwestie ich barwienia oraz alternatywne metody nanoszenia powłok. Kompleksowo przebadane zostaną kolejne mieszanki, oprócz tego ma zostać opracowana metoda kontroli jakości wyrobów antybakteryjnych, umożliwiająca w prosty sposób bezpośrednie lub pośrednie stwierdzenie obecności składnika antybakteryjnego w składzie powłoki. Wyniki pierwszej fazy projektu dowiodły, że oprócz ogólnej analizy wykonalności i przydatności danej substancji nierzadko potrzebny jest dodatkowy etap prac polegający na doborze substancji pod kątem określonego wyrobu, tak aby osiągnąć optymalny skład powłoki.
2011: druga faza projektu
Na bazie powyższych założeń Instytut Tworzyw Sztucznych oferuje przedsiębiorstwom możliwość uczestnictwa w programie „Powłoki antybakteryjne 2”, w ramach którego każda firma będzie prowadziła samodzielnie badania, co do których gwarantuje się poufność, również względem innych uczestników programu. W celu uzyskania wiarygodnych wyników co do skuteczności antybakteryjnej danej substancji niezbędne będą tradycyjne testy biologiczne. Dla zapewnienia jakości na etapie produkcji kluczowa jest również kwestia weryfikacji, czy wyrób rzeczywiście otrzymał dodatek antybakteryjny. W tym celu planuje się opracowanie prostej i taniej metody umożliwiającej sprawdzenie, czy składnik znalazł się w użytej mieszance. Mógłby to być np. czynnik, który naniesiony na powierzchnię wyrobu w obecności badanego składnika odbarwia się w określony sposób. Innym ważnym aspektem, który będzie brany pod uwagę w przypadku farb antybakteryjnych, jest kwestia ewentualnych zmian właściwości powłoki w wyniku zastosowania dodatków. Na przykład w wypadku antybakteryjnych tworzyw sztucznych stwierdza się zmianę ich właściwości mechanicznych, natomiast przezroczyste błyszczące lakiery zmieniają swoje cechy, jak np. odporność na działanie środków czyszczących, połysk czy szorstkość. Zmiany te zależą jednak w dużej mierze od zastosowanej kombinacji farby i składnika antybakteryjnego. Jeśli dodatkowo jednym ze składników farby są barwniki, może dochodzić do interakcji pomiędzy pigmentem a substancją bakteriobójczą. Na przykład, barwniki zawierające siarkę mogą osłabiać antybakteryjne działanie dodatków na bazie srebra. Z punktu widzenia lakierni istotną kwestią będzie również, czy ze względu na specyfikę nowych powłok konieczna będzie modernizacja istniejących urządzeń lub zmiana technologii. Zasadniczym celem badań nad nowymi powłokami jest wypracowanie takich technologii, które będą możliwe do zastosowania w każdym konwencjonalnym zakładzie. Z dotychczasowych doświadczeń wynika też na przykład, że dla osiągnięcia wysokiej jakości powłoki przy jednoczesnym zachowaniu wymaganych właściwości antybakteryjnych konieczne jest skrócenie czasu schnięcia.






